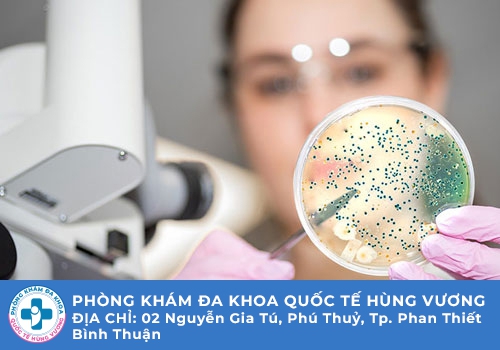

Có thắc mắc
Hỏi chuyên gia
Đặt hẹn online
Công ty TNHH MTV dịch vụ y tế Quốc Tế Hùng Vương
02 Nguyễn Gia Tú, Khu phố 14, Thành phố Phan Thiết, Bình Thuận
Liên lạc: 0252.7303.888
Xét nghiệm bệnh lậu là một trong những phương pháp giúp xác định chính xác bạn có đang mắc phải căn bệnh xã hội nguy hiểm đó hay không. Tuy nhiên điều mà rất nhiều bệnh nhân lo lắng là không biết nên chọn địa chỉ xét nghiệm bệnh lậu ở đâu chất lượng? Đặc biệt trong thời điểm hiện nay có rất nhiều các cơ sở xuất hiện với quảng cáo chuyên xét nghiệm và điều trị bệnh xã hội như bệnh lậu. Và để tìm được một địa chỉ chất lượng uy tín thì bạn đừng bỏ con những thông tin mà chúng tôi cập nhật dưới đây.

Trước khi tìm hiểu xem địa chỉ xét nghiệm bệnh lậu ở đâu chất lượng thì bạn cần biết bệnh lậu là căn bệnh như thế nào? Đây là căn bệnh thuộc nhóm bệnh xã hội Vô cùng nguy hiểm, đang trở thành mối đe dọa sức khỏe cho toàn cộng đồng. Bệnh xuất phát là do một loại vi khuẩn lậu cầu có tên Neisseria gonorrhoeae gây ra. Bệnh lậu chủ yếu lây nhiễm thông qua đường tình dục không an toàn Ngoài ra có thể bắt gặp ở một số con đường lây nhiễm khác như đường máu lây từ mẹ sang con qua quá trình mang thai hoặc lây nhiễm gián tiếp,...
Theo các chuyên gia thì vi khuẩn lậu thường hay trú ngụ tại các vị trí như vùng kín, hậu môn, họng, miệng, lưỡi,... Bệnh lậu là căn bệnh Vô cùng nguy hiểm và nếu không sớm phát hiện để điều trị có thể ảnh hưởng tiêu cực đến sức khỏe của người bệnh. Người bị bệnh lậu rất dễ bị viêm nhiễm sinh dục, chuyển biến thành ung thư, thậm chí là gây vô sinh, hiếm muộn, ảnh hưởng hạnh phúc gia đình.

Đây là căn bệnh có thời gian ủ bệnh ngắn chỉ từ 2 đến 9 ngày, với một số các dấu hiệu thường gặp ở nam và nữ giới như:
♦ Viêm nhiễm cơ quan sinh dục, cảm thấy ngứa ngáy và khó chịu, xuất hiện mùi hôi ở vùng kín.
♦ Ra nhiều khí hư ở nữ giới với màu sắc và tính chất khác lạ, niệu đạo nam giới có thể chảy mủ.
♦ Đi tiểu cảm thấy đau buốt, đi tiểu rát, có trường hợp còn đi tiểu ra máu.
♦ Nam giới cảm thấy đau đớn khi quan hệ tình dục, gặp khó khăn khi quan hệ, thậm chí là cảm giác tự ti, không còn ham muốn.
♦ Người bệnh có thể xuất hiện thêm các triệu chứng như buồn nôn, khó chịu, mệt mỏi cơ thể, nổi hạch, chán ăn,...
Nếu như xuất hiện những triệu chứng kể trên người bệnh cần chủ động tìm đến các cơ sở chuyên khoa để thực hiện xét nghiệm bệnh lậu. Và một điều mà bệnh nhân cần quan tâm là làm sao để lựa chọn được địa chỉ xét nghiệm bệnh lậu uy tín.

Để lựa chọn được những địa chỉ xét nghiệm bệnh lậu chất lượng và uy tín thì phải đáp ứng được các tiêu chí như sau:
► Cơ sở phải là cơ sở y tế uy tín được cấp phép hoạt động trong ngành y tế, đảm bảo an toàn và hiệu quả trong quy trình thăm khám và điều trị bệnh lậu, được đông đảo bệnh nhân tin tưởng.
► Địa chỉ phải có đội ngũ bác sĩ giỏi chuyên môn, nhiều kinh nghiệm, đảm bảo cho quá trình xét nghiệm và điều trị bệnh lậu diễn ra chính xác và mang đến hiệu quả cao.
► Cơ sở phải đầu tư về trang thiết bị đầy đủ, tiện nghi, các thiết bị liên tục được kiểm tra và cập nhật nhập khẩu từ các nước có y học phát triển, nhằm phục vụ nhu cầu khám chữa bệnh của người bệnh.

► Các phương pháp xét nghiệm và điều trị bệnh lậu tại cơ sở phải đa dạng, áp dụng được các công nghệ tiên tiến mới, nhằm đưa ra kết quả nhanh chóng, chính xác và điều trị bệnh hiệu quả.
► Mức chi phí cho việc xét nghiệm và điều trị bệnh xã hội phù hợp, được công khai minh bạch để bệnh nhân nắm bắt dự trù kinh phí và cảm thấy ân tâm hơn.

Một trong những cơ sở đáp ứng được các tiêu chí khi bệnh nhân lựa chọn địa chỉ xét nghiệm bệnh lậu đó là Phòng Khám Đa Khoa Quốc Tế Hùng Vương. Đây là phòng khám chuyên khoa có cơ sở đặt tại 02 Nguyễn Gia Tú, Khu phố 14, Thành phố Phan Thiết, Bình Thuận, bệnh nhân cần xét nghiệm và điều trị bệnh lậu hay các căn bệnh xã hội khác đều có thể yên tâm bởi vì:
Phòng khám sở hữu được đội ngũ các bác sĩ vừa giỏi chuyên môn, có kinh nghiệm khám và điều trị các bệnh xã hội, trong đó có bệnh lậu vô cùng nguy hiểm. Các bác sĩ còn chu đáo nhiệt tình trong việc hỗ trợ tư vấn tâm lý sức khỏe cho bệnh nhân.
Phòng khám đầu tư rất nhiều về cơ sở vật chất, có đầy đủ các phòng ban chức năng và không gian phòng bệnh sẽ được thiết kế đầy đủ tiện nghi. Ngoài ra hệ thống thiết bị, máy móc, vật tư y tế tại phòng khám đều sẽ được nhập khẩu từ các nước phát triển y học, giúp bệnh nhân có thể an tâm và tự tin hơn trong việc khám và điều trị bệnh.
Phòng khám áp dụng nhiều phương pháp xét nghiệm bệnh lậu dựa theo công nghệ cao, rất tiên tiến. Các phương pháp giúp bệnh nhân có được kết quả chẩn đoán chính xác trong thời gian nhanh chóng. Khi đã xác định chính xác tình trạng bệnh của bệnh nhân phòng khám cũng sẽ đưa ra phác đồ điều trị phù hợp. Các phương án điều trị sẽ tùy thuộc vào tình trạng bệnh và cố gắng mang đến hiệu quả cao trong việc điều trị.
Phòng khám cũng được đánh giá cao về dịch vụ y tế, khi cung cấp cho người bệnh nhiều tiện ích như có thể tiếp nhận tư vấn trực tuyến, đặt lịch khám trước thủ tục hành chính nhanh chóng đơn giản và bệnh nhân sẽ được hỗ trợ tối ưu khi lựa chọn cơ sở làm nơi thăm khám.
Mức chi phí tại phòng khám hợp lý nằm trong khả năng chi trả của hầu hết người bệnh. Phòng khám sẽ luôn có hướng dẫn cụ thể, công khai về chi phí và các hạng mục mà bệnh nhân phải chi trả, để bệnh nhân chủ động hơn trong việc chuẩn bị.
Phòng khám có thời gian làm việc rất linh hoạt có hoạt động ngoài giờ hành chính, nên hỗ trợ được cho người bệnh chủ động sắp xếp thời gian lựa chọn một khung giờ phù hợp, không ảnh hưởng đến công việc cá nhân.
Với những thông tin mà chúng tôi chia sẻ trên đây chắc hẳn bạn đã giải đáp được lo lắng về việc lựa chọn địa chỉ xét nghiệm bệnh lậu uy tín và an toàn. Việc lựa chọn cơ sở phù hợp không chỉ có kết quả xét nghiệm chính xác mà còn giúp ích trong việc điều trị. Nếu như bệnh nhân cần hỗ trợ thêm bất kỳ thông tin nào khác hãy trực tiếp liên lạc đến hotline 0252.7303.888 hoặc có thể nhắn tin vào ngay khung chat dưới đây.

Phòng Khám Đa Khoa Quốc Tế Hùng Vương địa chỉ: 02 Nguyễn Gia Tú, Khu phố 14, Thành phố Phan Thiết, Bình Thuận
- Đặt lịch hẹn qua số điện thoại: 0252.7303.888 để được đăng ký khám sớm không mất công chờ đợi.
- Đăng ký ngay để nhận tư vấn và dịch vụ ưu đãi: